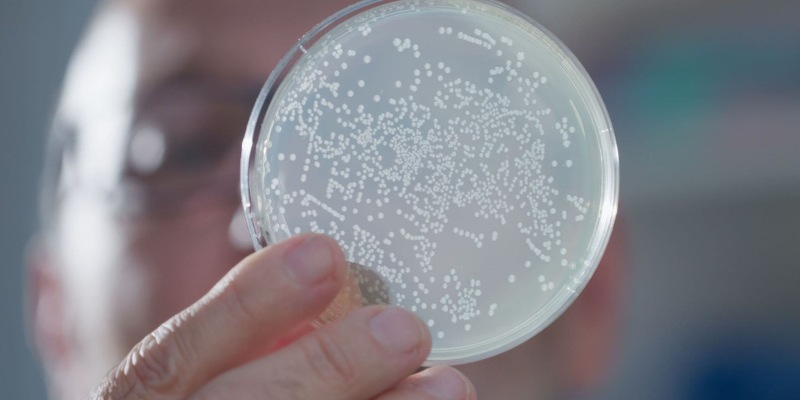
WissenHoch2 in 3sat über KI in der Medizin und winzige Antikörper - Foto: presseportal.de

WissenHoch2 in 3sat über KI in der Medizin und winzige Antikörper
29.05.2024 - 11:07:26WissenHoch2 in 3sat über KI in der Medizin und winzige Antikörper. Mainz - Kamele werden selten krank und liefern einen genialen Grundstoff für wirkungsvolle Medikamente: Winzige Antikörper, sogenannte Nanobodies, die sonst bei keinem anderen Säugetier zu finden sind. Die Wissenschaftsdokumentation "Winzige Antikörper: Boost fürs Immunsystem" am Donnerstag, 6. Juni 2024, um 20.15 Uhr, erzählt die Geschichte von der zufälligen Entdeckung der Nanobodies und ihrer Relevanz in der medizinischen Forschung. Im Anschluss, um 21.00 Uhr, befasst sich im Rahmen von "WissenHoch2" die Sendung "scobel – Gesund durch KI" mit der Bedeutung von Künstlicher Intelligenz in der Medizin.
Resistent gegen viele Krankheiten durch Nanobodies
Die 3sat-Wissenschaftsdokumentation "Winzige Antikörper: Boost fürs Immunsystem" zeigt, dass Nanobodies von Tieren aus der Familie der Kamele – dazu gehören etwa Trampeltiere, Dromedare, Lamas und Alpakas – in Bereiche des Körpers vordringen können, die für menschliche Antikörper unerreichbar sind. Die Familie der Kamele hat sich an extreme Bedingungen angepasst: Sie ertragen große Hitze, Dürre und Unterernährung – und sie sind resistent gegen viele Krankheiten. Mithilfe dieser Nanobodies werden völlig neue Medikamente und Diagnosemethoden entwickelt. So könnte schon bald Covid-19 bekämpft, neue Medikamente gegen Krebs und Alzheimer entwickelt und Malaria der Schrecken genommen werden. Die Nanobodies des einzigartigen Immunsystems der Kamelfamilie sind auch in der Lage, die Proteinrüstungen von gefährlichen Erregern wie den Milzbrandbakterien zu durchbrechen.
Künstliche Intelligenz in der Medizin auf dem Vormarsch
Im Anschluss, um 21.00 Uhr, folgt die Sendung "scobel – Gesund durch KI". Künstliche Intelligenz wird die Medizin revolutionieren. Algorithmen und neuronale Netze eröffnen ungeahnte Möglichkeiten für Prävention, Früherkennung, Diagnose und Therapie. Schon heute kann die KI in beliebig vielen Patientendaten Muster erkennen: Sie analysiert in kürzester Zeit Symptome, Therapien und Krankheitsbilder von vielen Patienten und zieht daraus Rückschlüsse auf die richtige Therapie für den Einzelnen. Durch die Kombination von Patienteninformationen mit den Daten zu Symptomen, Diagnose, Krankheitsverlauf und Therapie ist durch den Einsatz von KI ein deutlich individuelleres und präziseres Bild von Erkrankungen und deren Entstehen möglich. In der Diagnostik könnte es Ärzten weltweit schon bald möglich sein, mit Augmented-Reality-Brillen direkt in den menschlichen Körper zu blicken, und KI-gesteuerte Robotik unterstützt Chirurgen bei komplexen Eingriffen. Doch sind die Daten, auf deren Basis KI-Systeme lernen, ausreichend vielfältig? Welche ethischen oder datenschutzrechtlichen Fragen werden zu klären sein? Über diese und andere relevante Fragen diskutiert Gert Scobel mit seinen Gästen, darunter Eva Wolfangel, Journalistin, Kulturwissenschaftlerin und Expertin unter anderem für KI, Technikethik und Digitalisierung, und Prof. Dr. Björn Ommer, Physiker und Informatiker, LMU München.
"WissenHoch2" – ein Thema, zwei Formate: Um 20.15 Uhr beleuchtet eine Dokumentation relevante wissenschaftliche Fragen; um 21.00 Uhr diskutiert Gert Scobel das Thema mit seinen Gästen aus unterschiedlichen wissenschaftlichen Disziplinen.
Kontakt
Bei Fragen zur Pressemitteilung erreichen Sie Marion Leibrecht, ZDF-Kommunikation, telefonisch unter 06131 – 70-16478.
Sie erreichen die ZDF-Kommunikation per E-Mail unter pressedesk@zdf.de oder telefonisch unter 06131 – 70-12108.
Pressefotos
Pressefotos zur Sendung erhalten Sie als Download (nach Log-in), per E-Mail unter pressefoto@zdf.de oder telefonisch unter 06131 – 70-16100.
Weitere Informationen
Im 3sat-Pressetreff finden Sie ergänzend:
- die Pressemappe mit Video der Dokumentation
3sat – das Programm von ZDF, ORF, SRG und ARD
Pressekontakt:
Zweites Deutsches Fernsehen
HA Kommunikation/3sat Presse
Telefon: +49 - (0)6131 - 70-12108
Original-Content von: 3sat übermittelt durch news aktuell